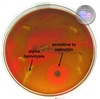

Otitis, sinusitis, diphtheria, pertussis Flashcards
(48 cards)
Inflammation of the external auditory canal
otitis externa
what is a major predisposing factor for otitis externa
moisture (swimmer’s ear)
what are the most common causes of otitis externa
- pseudomonas aeruginosa
- staphylococcus aureus
pseudomonas aeruginosa
- gram status
- shape
- form capsule?
- gram negative
- bacilli
- encapsulated
pseudomonas aeruginosa produces what pigments
-
pyocyanin: non-fluorescent bluish
- many strains produce
-
pyoverdin: fluorescent green
- nearly all strains produce
what function enables pseudomonas aeruginosa to produce pyocyanin and pyoverdin
- pyocyanin: generates ROS
- pyoverdin: sequesters iron (a siderophore)
staphylococcus aureus
- gram status
- shape
- capsule?
- gram positive
- cocci in clusters
- encapsulated
staphylococcus aureus: coagulase positive or negative
positive

staphylococcus aureus: what happens when it is put on blood agar
B-hemolytic: the area appears lightened (yellow) and transparent.

how is otitis externa diagnosed
- examination of ear
- gram stain
treatment of otitis externa
- topical
- acidifying agents
- topical corticosteroids
- oral abx if fever is present
what are the mot common bacterial causes of otitis media and sinusitis
- streptococcus pneumoniae (50%)
- haemophilus influenzae (20%)
- moraxella catarrhais (10%)
inflammation of the middle ear, including tympanic membrane and usually associated with a buildup of fluid in the middle ear space
otitis media

steptococcus pneuomonia
- gram status
- shape
- capsule?
- gram positive
- lancet-shaped diplococci
- virulent strains are encapsulated
steptococcus pneuomonia has what two distinguishing factors on blood agar
- a-hemolysis
- sensitive to optochin
Haemophilus influenzae
- gram status
- shape
- gram negative
- coccobacilli
moraxella catarrhalis
- gram status
- shape
- gram negative
- diplococci
moraxella catarrhalis has what distinguishing factors
- oxidase positive
- B-lactamase producer
diagnosis of otitis media
clinical presentation
DOC for acute bacterial otitis media
- amoxicillin
- chronic: tympanostomy tubes may be inserted
diagnosis of sinusitis
- clinical presentation and history
- CT scan?
causative agent of diphtheria
corynebacterium
corynebacterium
- gram status
- shape
- requires oxygen?
- gram positive
- pleomorphic bacilli
- grows aerobically on blood agar
which bacteria has a “Palisades,” “V,” “Chinese letters” appearance
corynebacterium


